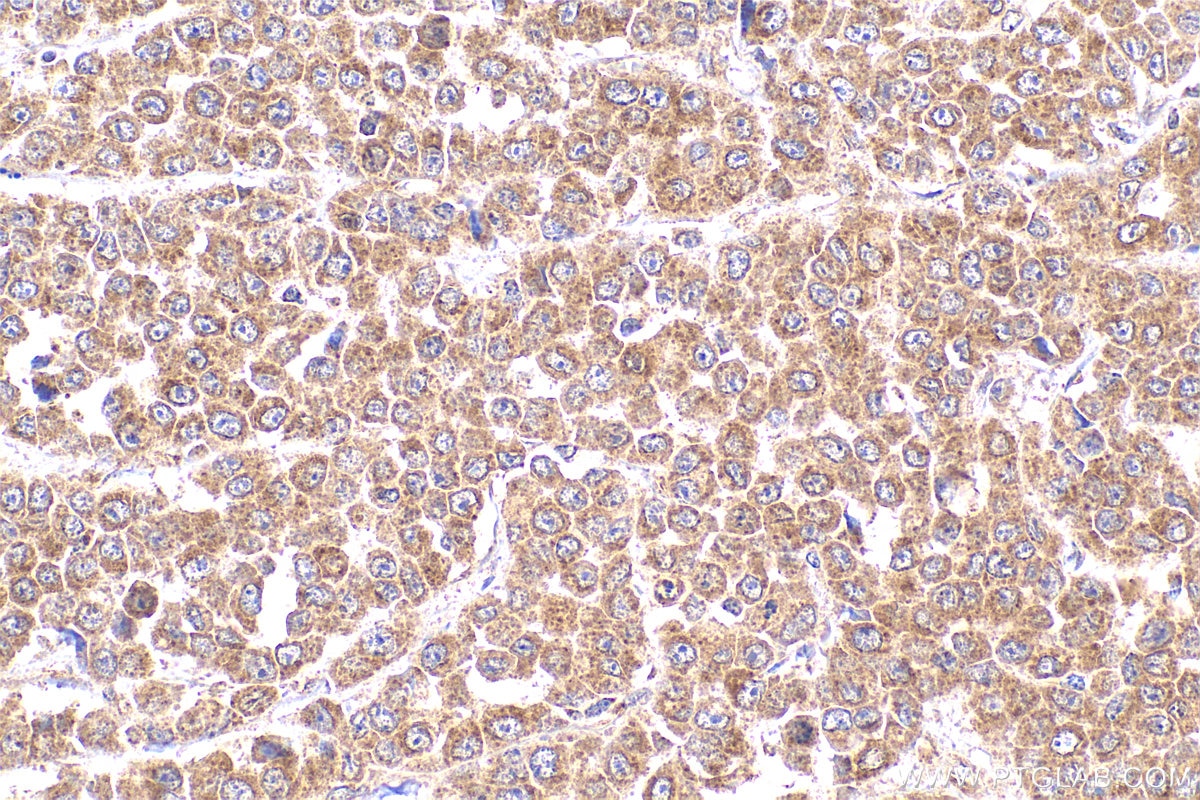
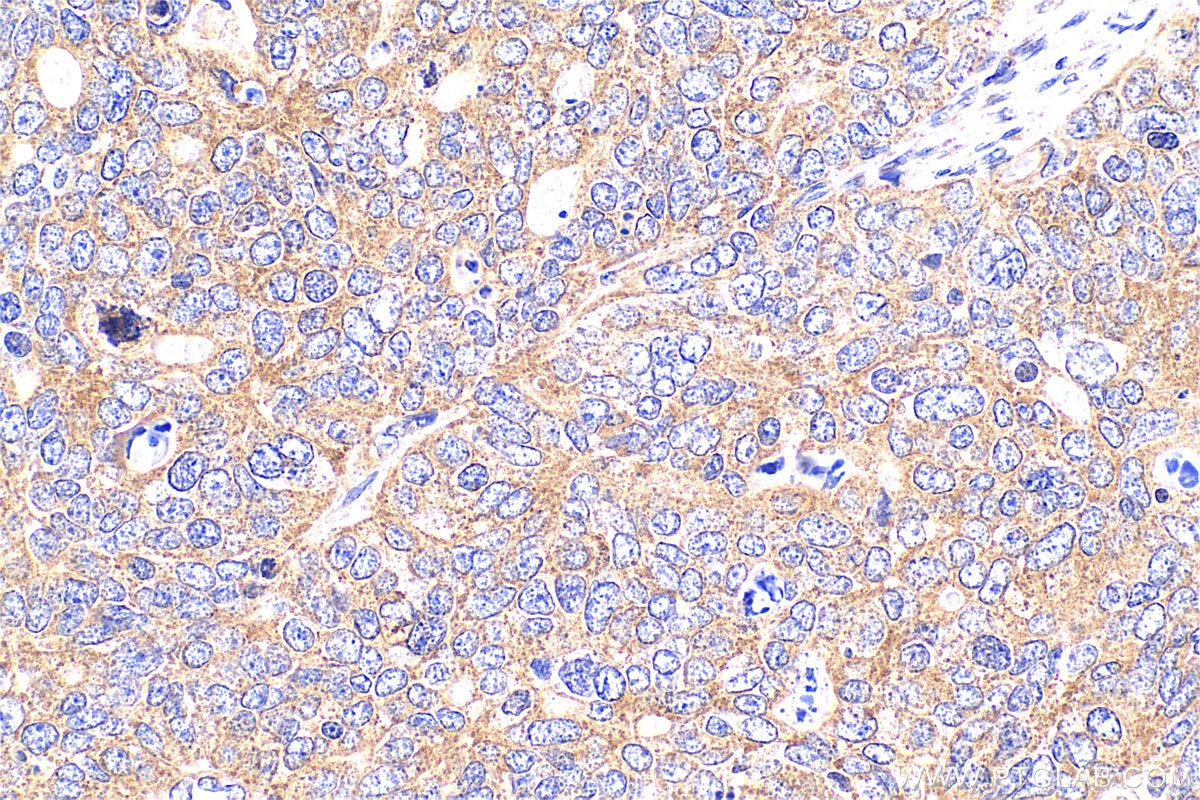

Tested Applications
| Positive WB detected in | HEK-293 cells, C2C12 cells, HeLa cells, C6 cells, Jurkat cells, MCF-7 cells |
| Positive IP detected in | HEK-293 cells |
| Positive IHC detected in | human colon cancer tissue, human heart tissue, human ovary tumor tissue Note: suggested antigen retrieval with TE buffer pH 9.0; (*) Alternatively, antigen retrieval may be performed with citrate buffer pH 6.0 |
Recommended dilution
| Application | Dilution |
|---|---|
| Western Blot (WB) | WB : 1:3000-1:10000 |
| Immunoprecipitation (IP) | IP : 0.5-4.0 ug for 1.0-3.0 mg of total protein lysate |
| Immunohistochemistry (IHC) | IHC : 1:50-1:500 |
| It is recommended that this reagent should be titrated in each testing system to obtain optimal results. | |
| Sample-dependent, Check data in validation data gallery. | |
Published Applications
| KD/KO | See 3 publications below |
| WB | See 19 publications below |
| IHC | See 3 publications below |
| IF | See 4 publications below |
| IP | See 1 publications below |
| CoIP | See 1 publications below |
Product Information
22117-1-AP targets MYPT1 in WB, IHC, IF, IP, CoIP, ELISA applications and shows reactivity with human, mouse, rat samples.
| Tested Reactivity | human, mouse, rat |
| Cited Reactivity | human, mouse, rat, pig |
| Host / Isotype | Rabbit / IgG |
| Class | Polyclonal |
| Type | Antibody |
| Immunogen |
CatNo: Ag17496 Product name: Recombinant human MYPT1 protein Source: e coli.-derived, PET28a Tag: 6*His Domain: 707-981 aa of BC111752 Sequence: AEKTIGRSRSTRTREQENEEKEKEEKEKQDKEKQEEKKESETSREDEYKQKYSRTYDETYQRYRPVSTSSSTTPSSSLSTMSSSLYASSQLNRPNSLVGITSAYSRGITKENEREGEKREEEKEGEDKSQPKSIRERRRPREKRRSTGVSFWTQDSDENEQEQQSDTEEGSNKKETQTDSISRYETSSTSAGDRYDSLLGRSGSYSYLEERKPYSSRLEKDDSTDFKKLYEQILAENEKLKAQLHDTNMELTDLKLQLEKATQRQERFADRSLLE Predict reactive species |
| Full Name | protein phosphatase 1, regulatory (inhibitor) subunit 12A |
| Calculated Molecular Weight | 1030 aa, 115 kDa |
| Observed Molecular Weight | 130 kDa |
| GenBank Accession Number | BC111752 |
| Gene Symbol | MYPT1 |
| Gene ID (NCBI) | 4659 |
| RRID | AB_11183753 |
| Conjugate | Unconjugated |
| Form | Liquid |
| Purification Method | Antigen affinity purification |
| UNIPROT ID | O14974 |
| Storage Buffer | PBS with 0.02% sodium azide and 50% glycerol, pH 7.3. |
| Storage Conditions | Store at -20°C. Stable for one year after shipment. Aliquoting is unnecessary for -20oC storage. 20ul sizes contain 0.1% BSA. |
Background Information
Myosin phosphatase target subunit 1(MYPT1), which is also called PPP1R12A, is one of the subunits of myosin phosphatase. Myosin phosphatase regulates the interaction of actin and myosin downstream of the guanosine triphosphatase Rho. The small guanosine triphosphatase Rho is implicated in myosin light chain (MLC) phosphorylation, which results in contraction of smooth muscle and interaction of actin and myosin in nonmuscle cells. The guanosine triphosphate (GTP)-bound, active form of RhoA (GTP.RhoA) specifically interacted with the myosin-binding subunit (MBS) of myosin phosphatase, which regulates the extent of phosphorylation of MLC. Rho-associated kinase (Rho-kinase), which is activated by GTP. RhoA, phosphorylated MBS and consequently inactivated myosin phosphatase. Overexpression of RhoA or activated RhoA in NIH3T3 cells increased phosphorylation of MBS and MLC. Thus, Rho appears to inhibit myosin phosphatase through the action of Rho-kinase. Phosphorylation of MYPT1 at Thr696 and Thr853 results in phosphatase inhibition and cytoskeletal reorganization. Several transcript variants encoding different isoforms have been found for this gene.
Protocols
| Product Specific Protocols | |
|---|---|
| IHC protocol for MYPT1 antibody 22117-1-AP | Download protocol |
| IP protocol for MYPT1 antibody 22117-1-AP | Download protocol |
| WB protocol for MYPT1 antibody 22117-1-AP | Download protocol |
| Standard Protocols | |
|---|---|
| Click here to view our Standard Protocols |
Publications
| Species | Application | Title |
|---|---|---|
Int J Mol Sci RhoA/ROCK Pathway Activation is Regulated by AT1 Receptor and Participates in Smooth Muscle Migration and Dedifferentiation via Promoting Actin Cytoskeleton Polymerization. | ||
Sci Rep MicroRNA-223 Attenuates Hypoxia-induced Vascular Remodeling by Targeting RhoB/MLC2 in Pulmonary Arterial Smooth Muscle Cells. | ||
Sci Rep Nicotine facilitates VSMC dysfunction through a miR-200b/RhoGDIA/cytoskeleton module. | ||
Cells Mitotic Acetylation of Microtubules Promotes Centrosomal PLK1 Recruitment and Is Required to Maintain Bipolar Spindle Homeostasis.
| ||
Food Funct Chlorogenic acid improves the intestinal barrier by relieving endoplasmic reticulum stress and inhibiting ROCK/MLCK signaling pathways. |
Reviews
The reviews below have been submitted by verified Proteintech customers who received an incentive for providing their feedback.
FH Siddharth (Verified Customer) (07-28-2023) | Good for western blotting. Band detected around 120 KDa.
|
FH Claudia (Verified Customer) (10-19-2021) | Unmasking microwave: potencia medium, ph6, 10 min., cool 35 min., room temperature.
|